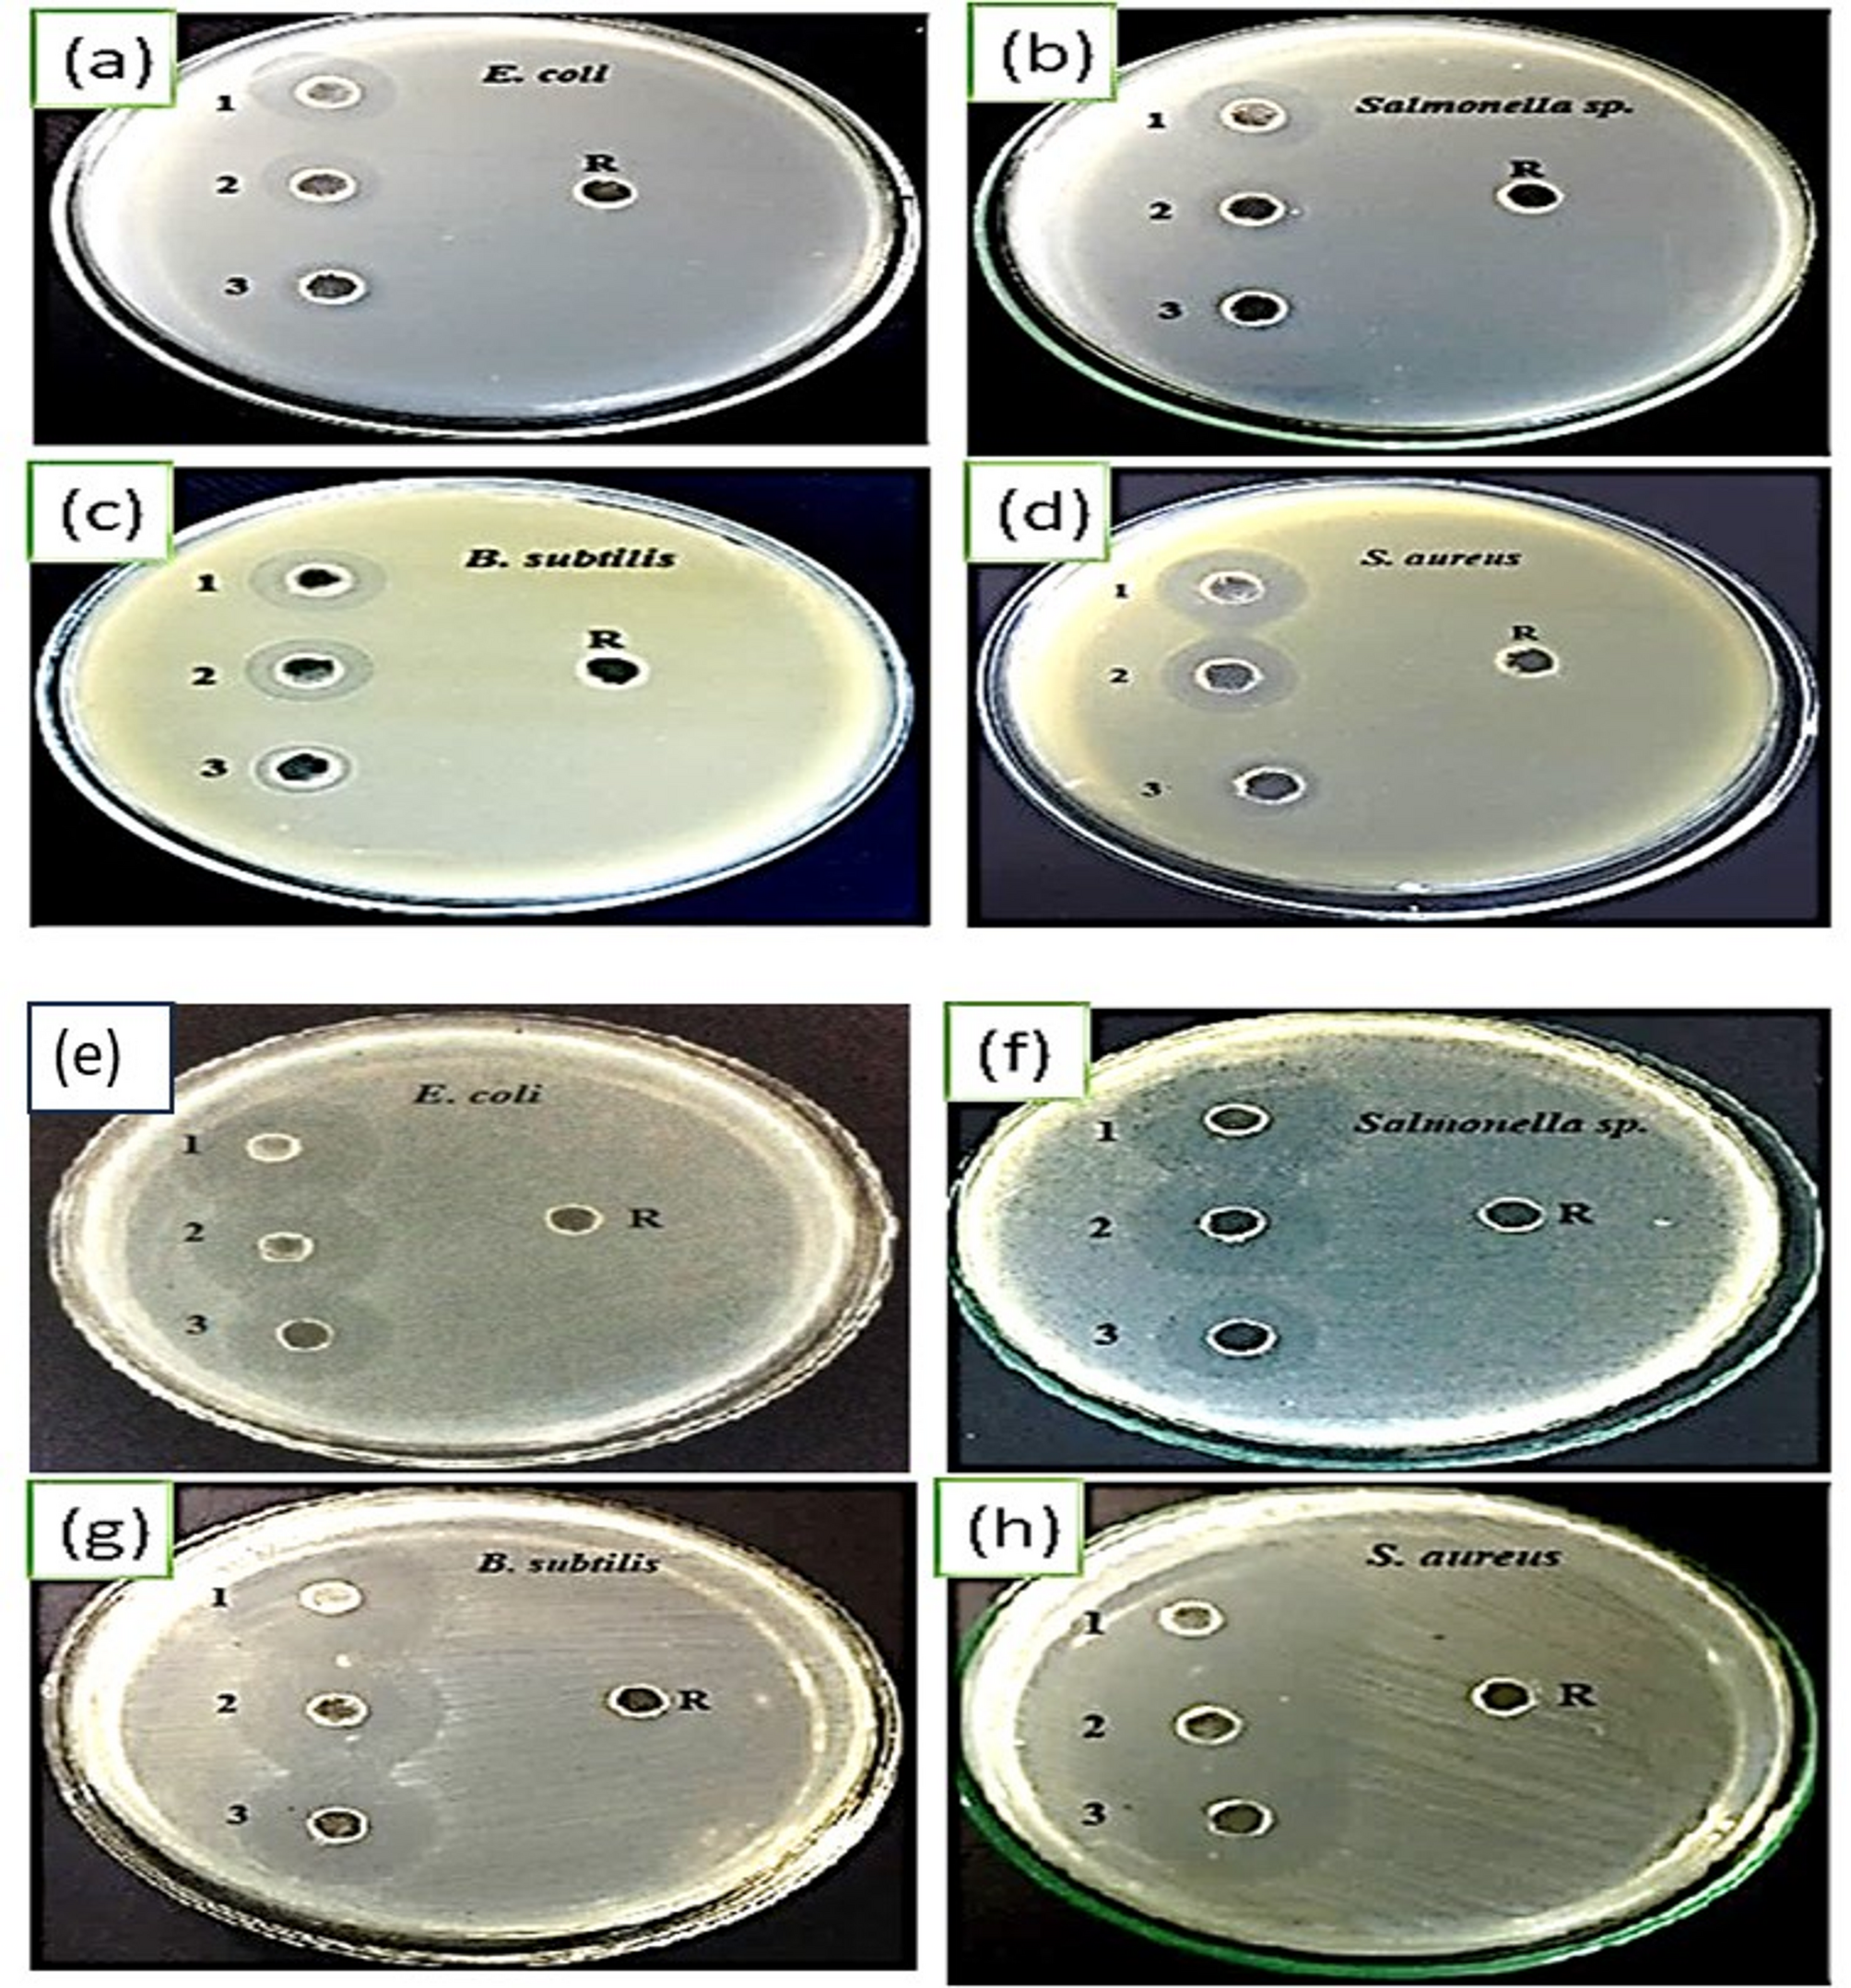
Fig. 3

Fig. 3

Antibacterial activity assays at varying concentrations (100, 200, and 400 ppm) of KCsSnI1.7Cl1.3 perovskite against the tested pathogens, conducted under dark conditions (Group A) and UV light exposure (Group B).
Antibacterial activity assays at varying concentrations (100, 200, and 400 ppm) of KCsSnI1.7Cl1.3 perovskite against the tested pathogens, conducted under dark conditions (Group A) and UV light exposure (Group B).